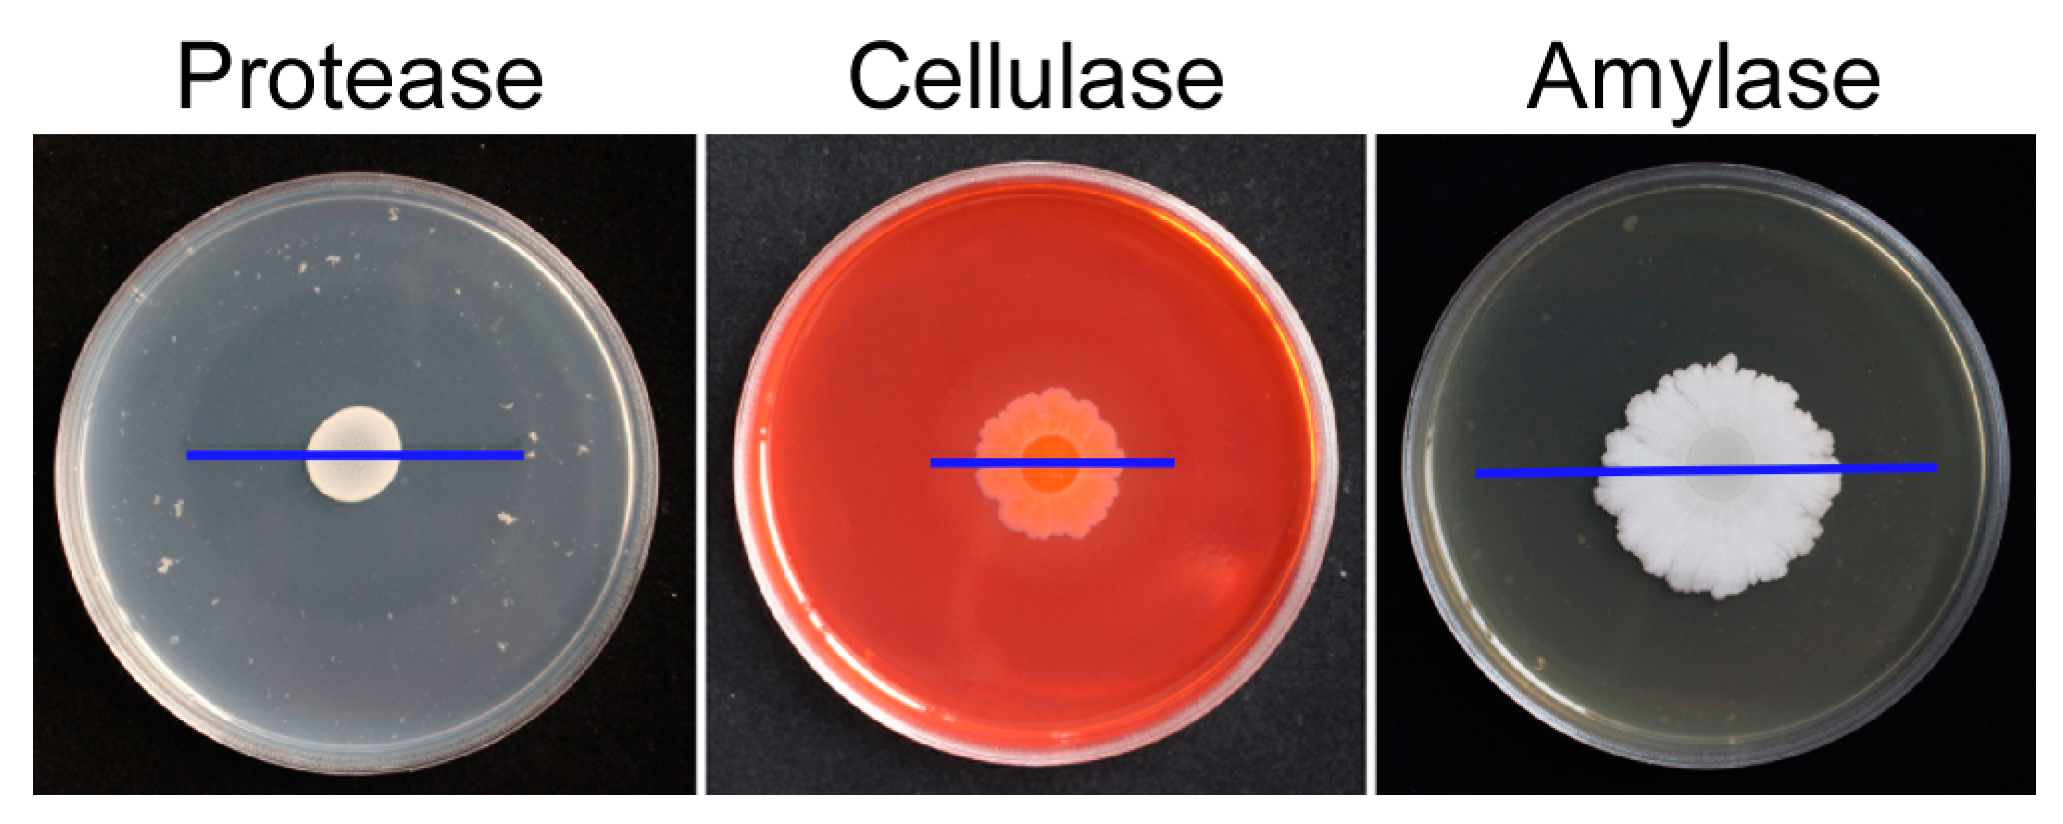

Isolation and Identification of Bacillus subtilis LY-1 and Its Antifungal and Growth-Promoting Effects
Abstract
:1. Introduction
2. Results
2.1. Isolation and Identification of Biocontrol Bacterial Strain LY-1
2.2. Antagonistic Activity of B. subtilis LY-1 against Peanut Fusarium spp.
2.3. Inhibition of Sporulation and Conidium Germination of three Fusarium spp. by B. subtilis LY-1 Culture Filtrate
2.4. Production of Extracellular Enzymes by B. subtilis LY-1
2.5. Amplification of Genes Encoding Antifungal Peptides
2.6. Growth-Promoting and Biocontrol Activity of B. subtilis LY-1 in Peanut Seedlings
3. Discussion
4. Materials and Methods
4.1. Isolation of Antagonistic Bacillus subtilis LY-1 from Wild Mint Rhizosphere
4.2. Molecular Identification of Isolate LY-1
4.3. Test Strain and Culture Condition
4.4. In Vitro Antagonistic Activity Assay
4.5. Antagonistic Activity of Extracellular Bacterial Metabolites
4.6. Antagonistic Activity of Bacterial Volatile Organic Compounds
4.7. Production of Extracellular Enzymes
4.8. Amplification of Antimicrobial Peptides Genes
4.9. Effects of B. subtilis Strain LY-1 on the Growth and Disease Level of Peanut
4.10. Statistical and Data Analyses
5. Conclusions
Supplementary Materials
Author Contributions
Funding
Data Availability Statement
Acknowledgments
Conflicts of Interest
References
- Bertioli, D.J.; Cannon, S.B.; Froenicke, L.; Huang, G.; Farmer, A.D.; Cannon, E.K.; Liu, X.; Gao, D.; Clevenger, J.; Dash, S.; et al. The genome sequences of Arachis duranensis and Arachis ipaensis, the diploid ancestors of cultivated peanut. Nat. Genet. 2016, 48, 438–446. [Google Scholar] [CrossRef]
- Bertioli, D.J.; Jenkins, J.; Clevenger, J.; Dudchenko, O.; Gao, D.; Seijo, G.; Leal-Bertioli, S.C.M.; Ren, L.; Farmer, A.D.; Pandey, M.K.; et al. The genome sequence of segmental allotetraploid peanut Arachis hypogaea. Nat. Genet. 2019, 51, 877–884. [Google Scholar] [CrossRef] [PubMed]
- Li, X.G.; Zhang, T.L.; Wang, X.X.; Hua, K.; Zhao, L.; Han, Z.M. The composition of root exudates from two different resistant peanut cultivars and their effects on the growth of soil-borne pathogen. Int. J. Biol. Sci. 2013, 9, 164–173. [Google Scholar] [CrossRef] [PubMed]
- Michielse, C.B.; Rep, M. Pathogen profile update: Fusarium oxysporum. Mol. Plant Pathol. 2009, 10, 311–324. [Google Scholar] [CrossRef]
- Andrés, J.A.; Pastor, N.A.; Ganuza, M.; Rovera, M.; Reynoso, M.M.; Torres, A. Biopesticides: An eco-friendly approach for the control of soilborne pathogens in peanut. In Microbial Inoculants in Sustainable Agricultural Productivity: Vol. 1: Research Perspectives; Singh, D.P., Singh, H.B., Prabha, R., Eds.; Springer: New Delhi, India, 2016; pp. 161–179. [Google Scholar]
- Li, E.; Li, Y.; Dai, X.; Yan, W.; Wang, G. Identification of Two Bacillus Strains with Antimicrobial Activity and Preliminary Evaluation of Their Biocontrol Efficiency. Horticulturae 2022, 8, 744. [Google Scholar] [CrossRef]
- Phong, N.H.; Pongnak, W.; Soytong, K.J.P.P.S. Antifungal activities of Chaetomium spp. against Fusarium wilt of tea. Plant Prot. Sci. 2016, 52, 10–17. [Google Scholar] [CrossRef]
- Fernando, W.G.D.; Ramarathnam, R.; Krishnamoorthy, A.S.; Savchuk, S.C.J.S.B.; Biochemistry. Identification and use of potential bacterial organic antifungal volatiles in biocontrol. Soil Biol. Biochem. 2005, 37, 955–964. [Google Scholar] [CrossRef]
- Zhang, J.-X.; Gu, Y.-B.; Chi, F.-M.; Ji, Z.-R.; Wu, J.-Y.; Dong, Q.-L.; Zhou, Z.-S. Bacillus amyloliquefaciens GB1 can effectively control apple valsa canker. Biol. Control 2015, 88, 1–7. [Google Scholar] [CrossRef]
- Alam, S.S.; Sakamoto, K.; Inubushi, K. Biocontrol efficiency of Fusarium wilt diseases by a root-colonizing fungus Penicillium sp. Soil Sci. Plant Nutr. 2011, 57, 204–212. [Google Scholar] [CrossRef]
- Rania, A.B.A.; Jabnoun-Khiareddine, H.; Nefzi, A.; Mokni-Tlili, S.; Daami-Remadi, M. Endophytic bacteria from Datura metel for plant growth promotion and bioprotection against Fusarium wilt in tomato. Biocontrol Sci. Technol. 2016, 26, 1139–1165. [Google Scholar] [CrossRef]
- Wang, J.; Cai, B.; Li, K.; Zhao, Y.; Li, C.; Liu, S.; Xiang, D.; Zhang, L.; Xie, J.; Wang, W. Biological Control of Fusarium oxysporum f. sp. cubense Tropical Race 4 in Banana Plantlets Using Newly Isolated Streptomyces sp. WHL7 from Marine Soft Coral. Plant Dis. 2022, 106, 254–259. [Google Scholar] [CrossRef] [PubMed]
- Brizuela, A.M.; Gálvez, L.; Arroyo, J.M.; Sánchez, S.; Palmero, D. Evaluation of Trichoderma spp. on Fusarium oxysporum f. sp. asparagi and Fusarium wilt Control in Asparagus Crop. Plants 2023, 12, 2846. [Google Scholar] [CrossRef] [PubMed]
- Obagwu, J.; Korsten, L. Integrated control of citrus green and blue molds using Bacillus subtilis in combination with sodium bicarbonate or hot water. Postharvest Biol. Technol. 2003, 28, 187–194. [Google Scholar] [CrossRef]
- Li, H.; Yue, H.; Li, L.; Liu, Y.; Zhang, H.; Wang, J.; Jiang, X. Seed biostimulant Bacillus sp. MGW9 improves the salt tolerance of maize during seed germination. AMB Express 2021, 11, 74. [Google Scholar] [CrossRef]
- Nicholson, W.L.; Galeano, B. UV resistance of Bacillus anthracis spores revisited: Validation of Bacillus subtilis spores as UV surrogates for spores of B. anthracis Sterne. Appl. Env. Microbiol. 2003, 69, 1327–1330. [Google Scholar] [CrossRef] [PubMed]
- Santoyo, G.; Orozco-Mosqueda, M.d.C.; Govindappa, M. Mechanisms of biocontrol and plant growth-promoting activity in soil bacterial species of Bacillus and Pseudomonas: A review. Biocontrol Sci. Technol. 2012, 22, 855–872. [Google Scholar] [CrossRef]
- Yamamoto, S.; Shiraishi, S.; Suzuki, S. Are cyclic lipopeptides produced by Bacillus amyloliquefaciens S13-3 responsible for the plant defence response in strawberry against Colletotrichum gloeosporioides? Lett. Appl. Microbiol. 2015, 60, 379–386. [Google Scholar] [CrossRef]
- Raaijmakers, J.M.; Leeman, M.; van Oorschot, M.M.P.; van der Sluis, I.; Schippers, B.; Bakker, P. Dose-response relationships in biological control of Fusarium wilt of radish by Pseudomonas spp. Phytopathology 1995, 85, 1075–1081. [Google Scholar] [CrossRef]
- Abdelmoteleb, A.; Moreno-Ramírez, L.; Valdez-Salas, B.; Seleiman, M.F.; El-Hendawy, S.; Aldhuwaib, K.J.; Alotaibi, M.; González-Mendoza, D. New Bacillus subtilis Strains Isolated from Prosopis glandulosa Rhizosphere for Suppressing Fusarium Spp. and Enhancing Growth of Gossypium hirsutum L. Biology 2022, 12, 73. [Google Scholar] [CrossRef]
- Mardanova, A.M.; Hadieva, G.F.; Lutfullin, M.T.; Khilyas, I.V.E.; Sharipova, M.R.J.A.S. Bacillus subtilis Strains with Antifungal Activity against the Phytopathogenic Fungi. Agric. Sci. 2017, 8, 1–20. [Google Scholar]
- Kim, P.I.; Ryu, J.; Kim, Y.H.; Chi, Y.T. Production of biosurfactant lipopeptides Iturin A, fengycin and surfactin A from Bacillus subtilis CMB32 for control of Colletotrichum gloeosporioides. J. Microbiol. Biotechnol. 2010, 20, 138–145. [Google Scholar] [CrossRef] [PubMed]
- Falardeau, J.; Wise, C.; Novitsky, L.; Avis, T.J. Ecological and mechanistic insights into the direct and indirect antimicrobial properties of Bacillus subtilis lipopeptides on plant pathogens. J. Chem. Ecol. 2013, 39, 869–878. [Google Scholar] [CrossRef] [PubMed]
- Baysal, O.; Lai, D.; Xu, H.H.; Siragusa, M.; Calışkan, M.; Carimi, F.; da Silva, J.A.; Tör, M. A proteomic approach provides new insights into the control of soil-borne plant pathogens by Bacillus species. PLoS ONE 2013, 8, e53182. [Google Scholar] [CrossRef] [PubMed]
- Hong, S.; Kim, T.Y.; Won, S.J.; Moon, J.H.; Ajuna, H.B.; Kim, K.Y.; Ahn, Y.S. Control of Fungal Diseases and Fruit Yield Improvement of Strawberry Using Bacillus velezensis CE 100. Microorganisms 2022, 10, 365. [Google Scholar] [CrossRef] [PubMed]
- Tan, Z.; Lin, B.; Zhang, R. A novel antifungal protein of Bacillus subtilis B25. Springerplus 2013, 2, 543. [Google Scholar] [CrossRef] [PubMed]
- Choudhary, D.K.; Johri, B.N. Interactions of Bacillus spp. and plants—With special reference to induced systemic resistance (ISR). Microbiol. Res. 2009, 164, 493–513. [Google Scholar] [CrossRef] [PubMed]
- Maheswari, N.U.; Sirchabai, T.P.J.B.B.R.A. Effect of Trichoderma species on Pythium aphanidermatum Causing Rhizome Rot of Turmeric. Biol. Biosci. Biotechnol. Res. Asia 2016, 8, 723–728. [Google Scholar] [CrossRef]
- Kopac, S.; Wang, Z.; Wiedenbeck, J.; Sherry, J.; Wu, M.; Cohan, F.M. Genomic heterogeneity and ecological speciation within one subspecies of Bacillus subtilis. Appl. Env. Microbiol. 2014, 80, 4842–4853. [Google Scholar] [CrossRef]
- Ntushelo, K.; Ledwaba, L.K.; Rauwane, M.E.; Adebo, O.A.; Njobeh, P.B. The Mode of Action of Bacillus Species against Fusarium graminearum, Tools for Investigation, and Future Prospects. Toxins 2019, 11, 606. [Google Scholar] [CrossRef]
- Gong, A.D.; Li, H.P.; Yuan, Q.S.; Song, X.S.; Yao, W.; He, W.J.; Zhang, J.B.; Liao, Y.C. Antagonistic mechanism of iturin A and plipastatin A from Bacillus amyloliquefaciens S76-3 from wheat spikes against Fusarium graminearum. PLoS ONE 2015, 10, e0116871. [Google Scholar] [CrossRef]
- Mulk, S.; Wahab, A.; Yasmin, H.; Mumtaz, S.; El-Serehy, H.A.; Khan, N.; Hassan, M.N. Prevalence of Wheat Associated Bacillus spp. and Their Bio-Control Efficacy Against Fusarium Root Rot. Front. Microbiol. 2021, 12, 798619. [Google Scholar] [CrossRef] [PubMed]
- Chen, Q.; Qiu, Y.; Yuan, Y.; Wang, K.; Wang, H. Biocontrol activity and action mechanism of Bacillus velezensis strain SDTB038 against Fusarium crown and root rot of tomato. Front. Microbiol. 2022, 13, 994716. [Google Scholar] [CrossRef]
- Hashem, A.; Tabassum, B.; Fathi Abd Allah, E. Bacillus subtilis: A plant-growth promoting rhizobacterium that also impacts biotic stress. Saudi J. Biol. Sci. 2019, 26, 1291–1297. [Google Scholar] [CrossRef] [PubMed]
- Tripathi, D.K.; Singh, V.P.; Kumar, D.; Chauhan, D.K. Impact of exogenous silicon addition on chromium uptake, growth, mineral elements, oxidative stress, antioxidant capacity, and leaf and root structures in rice seedlings exposed to hexavalent chromium. Acta Physiol. Plant. 2012, 34, 279–289. [Google Scholar] [CrossRef]
- Goswami, D.; Thakker, J.N.; Dhandhukia, P.C. Portraying mechanics of plant growth promoting rhizobacteria (PGPR): A review. Cogent Food Agric. 2016, 2, 1127500. [Google Scholar] [CrossRef]
- Chun, J.; Bae, K.S. Phylogenetic analysis of Bacillus subtilis and related taxa based on partial gyrA gene sequences. Antonie Van. Leeuwenhoek 2000, 78, 123–127. [Google Scholar] [CrossRef]
- Wang, B.; Yuan, J.; Zhang, J.; Shen, Z.; Zhang, M.; Li, R.; Ruan, Y.; Shen, Q. Effects of novel bioorganic fertilizer produced by Bacillus amyloliquefaciens W19 on antagonism of Fusarium wilt of banana. Biol. Fertil. Soils 2013, 49, 435–446. [Google Scholar] [CrossRef]
- Mullis, K.B.; Faloona, F.A. Specific synthesis of DNA in vitro via a polymerase-catalyzed chain reaction. Methods Enzymol. 1987, 155, 335–350. [Google Scholar] [CrossRef]
- Gao, Z.; Zhang, B.; Liu, H.; Han, J.; Zhang, Y.J.B.C. Identification of endophytic Bacillus velezensis ZSY-1 strain and antifungal activity of its volatile compounds against Alternaria solani and Botrytis cinerea. Biol. Control 2017, 105, 27–39. [Google Scholar] [CrossRef]
- Naik, P.R.; Raman, G.; Narayanan, K.B.; Sakthivel, N.J.B.M. Assessment of genetic and functional diversity of phosphate solubilizing fluorescent pseudomonads isolated from rhizospheric soil. BMC Microbiol. 2008, 8, 230. [Google Scholar] [CrossRef]
- Bellaouchi, R.; Abouloifa, H.; Rokni, Y.; Hasnaoui, A.; Ghabbour, N.; Hakkou, A.; Bechchari, A.; Asehraou, A. Characterization and optimization of extracellular enzymes production by Aspergillus niger strains isolated from date by-products. J. Genet. Eng. Biotechnol. 2021, 19, 50. [Google Scholar] [CrossRef] [PubMed]
- Ghose, T.K. Measurement of cellulase activities. Pure Appl. Chem. 1987, 59, 257–268. [Google Scholar] [CrossRef]

| Degrading Enzymes | A(C) | A(T) | ΔA | Activity (mg/h/mL) |
|---|---|---|---|---|
| Chitinase | 0.064 ± 0.002 | 0.088 ± 0.002 | 0.024 | 1.167 |
| β-1,3-glucanase | 0.036 ± 0.001 | 0.297 ± 0.001 | 0.261 | 2.925 |
Disclaimer/Publisher’s Note: The statements, opinions and data contained in all publications are solely those of the individual author(s) and contributor(s) and not of MDPI and/or the editor(s). MDPI and/or the editor(s) disclaim responsibility for any injury to people or property resulting from any ideas, methods, instructions or products referred to in the content. |
© 2023 by the authors. Licensee MDPI, Basel, Switzerland. This article is an open access article distributed under the terms and conditions of the Creative Commons Attribution (CC BY) license (https://creativecommons.org/licenses/by/4.0/).
Share and Cite
Li, Y.; Zhang, X.; He, K.; Song, X.; Yu, J.; Guo, Z.; Xu, M. Isolation and Identification of Bacillus subtilis LY-1 and Its Antifungal and Growth-Promoting Effects. Plants 2023, 12, 4158. https://doi.org/10.3390/plants12244158
Li Y, Zhang X, He K, Song X, Yu J, Guo Z, Xu M. Isolation and Identification of Bacillus subtilis LY-1 and Its Antifungal and Growth-Promoting Effects. Plants. 2023; 12(24):4158. https://doi.org/10.3390/plants12244158
Chicago/Turabian StyleLi, Ying, Xia Zhang, Kang He, Xinying Song, Jing Yu, Zhiqing Guo, and Manlin Xu. 2023. "Isolation and Identification of Bacillus subtilis LY-1 and Its Antifungal and Growth-Promoting Effects" Plants 12, no. 24: 4158. https://doi.org/10.3390/plants12244158
APA StyleLi, Y., Zhang, X., He, K., Song, X., Yu, J., Guo, Z., & Xu, M. (2023). Isolation and Identification of Bacillus subtilis LY-1 and Its Antifungal and Growth-Promoting Effects. Plants, 12(24), 4158. https://doi.org/10.3390/plants12244158

